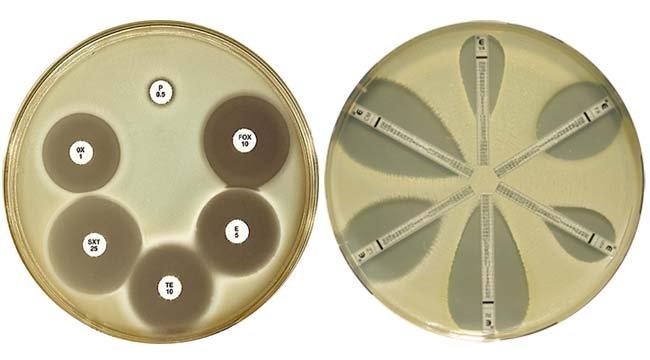

Press release
Antimicrobial Susceptibility Testing Market 2021 Global Industry Forecasts Analysis, Competitive Landscape and Key Regions Analysis | Grow at a CAGR of 5.3%
Antimicrobial susceptibility testing (AST) is a laboratory procedure carried out to recognize which antimicrobial regimen is particularly effective for individual patients. Antimicrobial susceptibility testing is adopted to determine the existence of bacteria and fungi in the body and to decide which specific antibiotics a particular bacteria or fungus is sensitive to. With the increase in pandemic and epidemic situations across the globe, huge numbers of diseases are also transmitting from person to person which is escalating the demand for antimicrobial susceptibility testing and is acting as a driver for the antimicrobial susceptibility testing market.To get a holistic SAMPLE of the report, please click @ https://www.supplydemandmarketresearch.com/home/contact/1496993?ref=Sample-and-Brochure&toccode=SDMRME1496993
The global antimicrobial susceptibility testing market in 2020 was approximately USD 3.0 Billion. The market is expected to grow at a CAGR of 5.3% and is anticipated to reach around USD 4.2 Billion by 2025. The strict government regulations on new products and instruments approval will likely to influence the antimicrobial susceptibility testing market. The genomic identification method is observed as a domain in which more developments can be made in order to develop new testing methods which will detect pathogen susceptibility precisely and in less time. This opportunity will support in boosting the antimicrobial susceptibility testing market in coming years. However, the high cost of automated ID/AST systems is likely to hamper the market growth.
The rise in technological innovations in designing the products for better quality, ease of use and better performance is expected to continue to intensify the level of competition among the companies to expand their product portfolios by incorporating innovative features, into their product. Key players in the market are Biomérieux, Danaher, BD, Thermo Fisher, Bio-Rad, Hi-Media, Merlin, Liofilchem, Accelerate Diagnostics, Alifax, Creative Diagnostics, Merck Group, Synbiosis, Bioanalyse, Zhuhai Dl Biotech and Others.
To get this report at a profitable rate @ https://www.supplydemandmarketresearch.com/home/contact/1496993?ref=Discount&toccode=SDMRME1496993
Based On The Basis Of Application, The Global Antimicrobial Susceptibility Testing Market Segmented Into
Clinical Diagnostics
Drug Discovery and Development
Epidemiology, Other Applications
Based On The Basis Of Product, The Global Antimicrobial Susceptibility Testing Market Segmented Into
Antibacterial Susceptibility Testing
Antifungal Susceptibility Testing
Antiparasitic Susceptibility Testing
Other Susceptibility Testing
Based On The Basis Of Region, The Global Antimicrobial Susceptibility Testing Market Segmented Into
Asia-Pacific [China, Southeast Asia, India, Japan, Korea, Western Asia]
Europe [Germany, UK, France, Italy, Russia, Spain, Netherlands, Turkey, Switzerland]
North America [United States, Canada, Mexico]
Middle East & Africa [GCC, North Africa, South Africa]
South America [Brazil, Argentina, Columbia, Chile, Peru]
Report Highlights
Global and China Antimicrobial Susceptibility Testing Market sizes from 2017 to 2024
Market growth projections through 2024 and the resultant market forecast for 2024
Impact of the market dynamics including market drivers, restraints and opportunities in the market size
Key industry trends, product trends, and application trends
Major driving/ leading segmentations, regions and countries in the Global and China Antimicrobial Susceptibility Testing Market
Competitive analysis with comprehensive company profiles of the leading industry players
In-depth analysis on growth and expansion strategies adopted by market players and their resulting effect on market growth and competition
Buy Complete Copy of this Report Avail 20% Discount Use Coupon [SDMR20] @ https://www.supplydemandmarketresearch.com/home/purchase?code=SDMRME1496993
The customization research services cover the additional custom report features such as additional regional and country level analysis as per the client requirements.
Contact Us:
SUPPLY DEMAND MARKET RESEARCH
Mr. Charles Lee
302-20 Misssisauga Valley Blvd, Missisauga,
L5A 3S1, Toronto, Canada
Phone Number: +12764775910
Email- info@supplydemandmarketresearch.com
This release was published on openPR.
Permanent link to this press release:
Copy
Please set a link in the press area of your homepage to this press release on openPR. openPR disclaims liability for any content contained in this release.
You can edit or delete your press release Antimicrobial Susceptibility Testing Market 2021 Global Industry Forecasts Analysis, Competitive Landscape and Key Regions Analysis | Grow at a CAGR of 5.3% here
News-ID: 2331728 • Views: …
More Releases from Supply Demand Market Research
South Korea Flounder Market Anticipated to grow at a CAGR of 8% from 2023-2030
The South Korea flounder is anticipated to grow at a CAGR% of 8.0% from 2022-2030. The factors contributing towards the high growth are flounders such as halibut and turbot high-protein and low-calorie food, helps to re-solve the nutritional imbalance from diet because of its rich minerals, carbohydrates and vitamins despite low-calorie. They also offer medical benefits as liver of halibut contains lots of vitamin B1 and B2, which is effective…
Global Flounder Market Anticipated to reach USD 56 Billion by 2030
The global flounder market is anticipated to reach USD 56 Billion by 2030, growing at a CAGR% of 8.0% from 2022-2030. The factors contributing towards the high growth are flounders such as halibut and turbot high-protein and low-calorie food, helps to re-solve the nutritional imbalance from diet because of its rich minerals, carbohydrates and vitamins despite low-calorie. They also offer medical benefits as liver of halibut contains lots of vitamin…
Global Seafood Market Anticipated to reach USD 730 Billion by 2030
The global seafood market is anticipated to reach USD 730 Billion by 2030, growing at a CAGR% of 8.9% from 2022-2030. The factors contributing towards the high growth are increased disposable income, awareness of fish being used as an ingredient in healthy food is growing. USA the government plans to sanction illegal fishing activities, actively promote fair trade, and promote strategies to promote the fishing industry through detailed strategies such…
Robotic Palletizers Market Is Expected to Reach US$11.98 Billion by 2033
The global robotic palletizers market is anticipated to reach $11.98 billion by 2033, presenting a 2023-2033 CAGR of 8.3%. The factors contributing towards the growth include the emerging Industry 4.0, a large scope for AI innovation, an increasing adoption of advanced industrial robotics to improve productivity and safety in manufacturing sectors, and the increasing government initiatives.
The report is highlighted with 122 tables and 96 figures, this 209-page report "Global Robotic…
More Releases for Susceptibility
Global Antimicrobial Susceptibility Testing Market to Reach USD 9.05 Billion by …
According to a new report by Maximize Market Research, the global antimicrobial susceptibility testing market was valued at USD 5.85 billion in 2024 and is projected to reach USD 9.05 billion by 2032, growing at a CAGR of 5.6 % from 2025 to 2032. The forecast underscores escalating demand across hospitals, clinics, and diagnostic programs worldwide.
For full access to the data, request a sample report now :https://www.maximizemarketresearch.com/request-sample/1281/
♦Key Highlights
Market Size &…
Antimicrobial Susceptibility Testing Market Forecast: Rising Demand in Healthcar …
Antimicrobial Susceptibility Testing Market Poised to Reach $8.12 Billion by 2030
The global antimicrobial susceptibility testing (AST) market is projected to grow significantly, reaching an estimated $8.12 billion by 2030, up from $5.54 billion in 2023, with a Compound Annual Growth Rate (CAGR) of 5.6% during the forecast period from 2024 to 2030.
Eager to discover what's within? Secure your sample copy of the report today:https://www.maximizemarketresearch.com/request-sample/1281/
Competitive Landscape and Regional Demand
The AST…
Antimicrobial Susceptibility Testing Market Developments | Business Report 2025- …
"𝐄𝐧𝐚𝐛𝐥𝐢𝐧𝐠 𝐁𝐮𝐬𝐢𝐧𝐞𝐬𝐬𝐞𝐬 𝐰𝐢𝐭𝐡 𝐂𝐮𝐭𝐭𝐢𝐧𝐠-𝐄𝐝𝐠𝐞 𝐌𝐚𝐫𝐤𝐞𝐭 𝐒𝐨𝐥𝐮𝐭𝐢𝐨𝐧𝐬 𝐟𝐨𝐫 𝐈𝐧𝐭𝐞𝐥𝐥𝐢𝐠𝐞𝐧𝐭 𝐃𝐞𝐜𝐢𝐬𝐢𝐨𝐧-𝐌𝐚𝐤𝐢𝐧𝐠"
The global antimicrobial susceptibility test market is projected to reach USD 5.02 billion by 2034 from USD 3.10 billion in 2022, at a CAGR of 5.5% from 2024 to 2034.
Antimicrobial Susceptibility Testing 𝐌𝐚𝐫𝐤𝐞𝐭 𝐒𝐢𝐳𝐞, 𝐒𝐜𝐨𝐩𝐞, 𝐚𝐧𝐝 𝐅𝐨𝐫𝐞𝐜𝐚𝐬𝐭 𝟐𝟎𝟐5-𝟐𝟎𝟑𝟒 𝐫𝐞𝐩𝐨𝐫𝐭 𝐡𝐚𝐬 𝐛𝐞𝐞𝐧 𝐚𝐝𝐝𝐞𝐝 𝐭𝐨 𝐄𝐱𝐚𝐜𝐭𝐢𝐭𝐮𝐝𝐞 𝐂𝐨𝐧𝐬𝐮𝐥𝐭𝐚𝐧𝐜𝐲'𝐬 𝐜𝐨𝐦𝐩𝐫𝐞𝐡𝐞𝐧𝐬𝐢𝐯𝐞 𝐦𝐚𝐫𝐤𝐞𝐭 𝐫𝐞𝐬𝐞𝐚𝐫𝐜𝐡 𝐜𝐨𝐥𝐥𝐞𝐜𝐭𝐢𝐨𝐧. The Global Antimicrobial Susceptibility Testing Market Study, a comprehensive analysis of the market…
Antimicrobial Susceptibility Testing Instrument Market Size 2024 to 2031.
Market Overview and Report Coverage
An Antimicrobial Susceptibility Testing Instrument is a device used in clinical microbiology laboratories to determine the effectiveness of antibiotics against specific bacteria strains. These instruments play a crucial role in guiding healthcare professionals in selecting appropriate antibiotic treatment for infections.
The current outlook for the Antimicrobial Susceptibility Testing Instrument Market is promising, with a projected CAGR of 9.80% during the forecasted period. Factors driving this…
Antimicrobial Susceptibility Testing Market
Redding California,March 19, 2024 - Meticulous Research®, a distinguished leader in global market research, announces the release of its latest report titled "Antimicrobial Susceptibility Testing Market." This comprehensive study provides valuable insights into the market landscape, forecasting significant growth and pivotal trends shaping the industry landscape.
Download free sample report here: https://www.meticulousresearch.com/download-sample-report/cp_id=5062
The Antimicrobial Susceptibility Testing Market is projected to burgeon to $5.99 billion by 2028, exhibiting a robust CAGR of approximately…
Antimicrobial Susceptibility Testing Market Analysis: Trends, Challenges, and Op …
According to the report published by Allied Market Research, the global antimicrobial susceptibility testing market generated $3.04 billion in 2020, and is anticipated to reach $4.73 billion by 2030, manifesting a CAGR of 5.8% from 2021 to 2030. The report offers an in-depth analysis of the market size, emerging and current trends, future estimations, and key players.
The global antimicrobial susceptibility testing market is experiencing growth driven by key factors such…